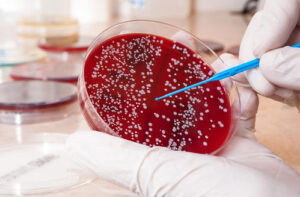
Лечение рака крови в Израиле

Гематологические центры Израиля на протяжении многих лет привлекают зарубежных пациентов с онкологическими заболеваниями кроветворной системы, нуждающихся не просто в стандартной терапии, а в эффективной и своевременной медицинской помощи. В израильских клиниках накоплен большой опыт ведения сложных и агрессивных форм лейкозов, лимфом и других онкозаболеваний крови, включая случаи, ранее признанные неизлечимыми. Лечение рака крови в Израиле подразумевает применение современных лекарственных схем, высокодозной химиотерапии, иммунных и клеточных методик, а также трансплантацию костного мозга с тщательным подбором совместимого донора. Точный диагноз и разработка плана терапии занимают считанные дни, что имеет решающее значение в случае быстро прогрессирующих форм заболевания.
Не менее важную роль для иностранных пациентов играет организация лечебного процесса. Израильские клиники обеспечивают четкую координацию всех этапов — от подтверждения первичного диагноза до завершения основного курса терапии и наблюдения. На сайтах клиник публикуются отзывы, в которых пациенты отмечают профессионализм врачей-гематологов, внимательное отношение персонала и помощь сопровождающего в решении организационных и бытовых вопросов. Дополнительным преимуществом выступает прозрачная стоимость лечения, часто более доступная по сравнению с аналогичными программами терапии в США и ряде европейских стран.
О заболевании
Рак крови характеризуется стремительным ростом аномальных кровяных клеток в костном мозге. Выделяют различные виды онкозаболеваний кроветворной системы, наиболее распространенными из которых являются лейкемии, лимфомы и множественная миелома. Причины рака крови заключаются в возникновении в кровяных клетках генных мутаций, в результате чего они бесконтрольно размножаются, вытесняя из костного мозга нормальные стволовые клетки крови. Учитывая, что раковые клетки крови не выполняют своих функций, а здоровых постепенно становится все меньше, внутренние органы не снабжаются достаточным количеством кислорода, организм не борется с инфекциями, возникают частые кровотечения.
Рак крови характеризуется стремительным ростом аномальных кровяных клеток в костном мозге. Выделяют различные виды онкозаболеваний кроветворной системы, наиболее распространенными из которых являются лейкемии, лимфомы и множественная миелома. Причины рака крови заключаются в возникновении в кровяных клетках генных мутаций, в результате чего они бесконтрольно размножаются, вытесняя из костного мозга нормальные стволовые клетки крови. Учитывая, что раковые клетки крови не выполняют своих функций, а здоровых постепенно становится все меньше, внутренние органы не снабжаются достаточным количеством кислорода, организм не борется с инфекциями, возникают частые кровотечения.
Известны факторы, повышающие риск возникновения рака крови:
- возраст и пол;
- вредные привычки (прежде всего, курение);
- воздействие химических и физических канцерогенов;
- предшествующая химиолучевая терапия;
- отягощенная наследственность;
- некоторые аутоиммунные нарушения;
- генетические расстройства.
Клинические признаки рака крови зависят от типа заболевания. Наиболее распространенные симптомы включают:
- повышенную утомляемость и слабость;
- одышку;
- увеличение лимфатических узлов;
- частые инфекционные заболевания;
- постоянную субфебрильную температуру;
- ночное потение;
- боль в костях и суставах;
- необъяснимое похудение;
- синяки, мелкие кровоизлияния.
Прогноз, в целом, благоприятный и зависит от стадии, на которой поставлен диагноз и проведена грамотная терапия.
Методы лечения заболевания
В Израиле программа лечения рака крови составляется в зависимости от типа и стадии заболевания, молекулярных характеристик опухолевых клеток, общего состояния пациента. Основная цель терапии заключается в достижении стойкой ремиссии и, по возможности, полного излечения, либо длительного контроля при хронических формах патологии.
Химиотерапия
Химиотерапия является основным методом лечения рака крови. В израильских клиниках применяются современные протоколы, включающие комбинации нескольких цитостатических препаратов (полихимиотерапия) с точно рассчитанными дозировками и интервалами введения. Это позволяет эффективно подавлять злокачественные клетки и одновременно снижать токсическую нагрузку на организм. При острых лейкозах химиотерапия проводится в несколько этапов — индукция ремиссии, консолидация и поддерживающее лечение.
Лучевая терапия
Облучение направлено на повреждение ДНК злокачественных клеток крови, что препятствует их размножению. Сеансы лучевой терапии также назначаются в качестве паллиативной помощи для облегчения болезненных симптомов. Как правило, радиотерапия сочетается с другими методами противоопухолевой терапии. В израильских клиниках радиотерапия проводится на современных установках, по программам, позволяющим модулировать дозу облучения и направление радиоактивных лучей. Таким образом гарантируется максимальное сохранение здоровых тканей.
Таргетная терапия
Таргетные препараты воздействуют на конкретные молекулярные механизмы, обеспечивающие рост и деление аномальных клеток. В Израиле такие препараты подбираются после углубленного молекулярно-генетического анализа, что особенно важно при хроническом миелолейкозе, некоторых формах лимфом и миеломы. Таргетные препараты распознают исключительно опухолевые клетки, не повреждая здоровые, чем и объясняется тот факт, что этот метод переносится легче классической химиотерапии и может длительно применяться, в том числе в амбулаторном режиме.
Иммунотерапия
Препараты на основе моноклональных антител и другие виды иммунопрепаратов активируют противоопухолевый иммунитет пациента, стимулируют способность безошибочно распознавать и атаковать злокачественные клетки. При лечении разных типов рака крови такой подход особенно эффективен в случае резистентных к проводимой терапии и рецидивирующих форм заболевания.
CAR-T-клеточная терапия
После проведения курсов химиотерапии во многих случаях назначается CAR-T-терапия (Chimeric Antigen Therapy). Эта инновационная методика основывается на выработке в лабораторных условиях у Т-лимфоцитов пациента способности атаковать аномальные кровяные клетки. Полученные у пациента Т-клетки модифицируются с помощью генно-инженерных методик и становятся способными распознавать злокачественные клетки крови, преодолевая их маскировку. В Израиле CAR-T-терапия назначается при определенных видах лейкозов, в том числе у пациентов, которым не помогли стандартные методы лечения.
Трансплантация костного мозга
При агрессивных и рецидивирующих формах рака крови назначается трансплантация костного мозга. Различают аутологичную трансплантацию, при которой пациенту вводятся собственные стволовые клетки, полученные до проведения курсов высокодозной химиотерапии. После уничтожения раковых клеток под влиянием химиопрепаратов в кровоток пациента возвращаются нормальные гемопоэтические стволовые клетки, дающие начало здоровым клеткам крови. Существует также аллогенная трансплантация, когда поврежденный костный мозг замещается клетками совместимого донора. В израильских клиниках созданы все условия для успешного проведения трансплантации и ведения пациента после процедуры, избегая осложнений и повышая процент выживаемости.
Поддерживающая и сопроводительная терапия
Большое внимание уделяется лечению осложнений и поддержке организма во время основного курса лечения. В израильских клиниках тщательно соблюдаются правила профилактики инфекционных заболеваний, проводится коррекция анемии и нарушений свертываемости, контроль побочных эффектов и возвращение пациента к привычной активной жизни.
Методы диагностики заболевания
Квалификация и опыт онкологов-гематологов, оснащение израильских клиник новейшим оборудованием позволяют поставить точный диагноз и разработать программу лечения за три дня.
Первый день
Прибыв в клинику, пациент направляется на консультацию лечащего гематолога. Врач изучает предоставленную медицинскую документацию, проводит поверхностный осмотр и назначает необходимые исследования.
Второй день
Проведение исследований:
- лабораторных анализов крови (общий и биохимический, тесты на определенные онкомаркеры);
- иммунофенотипирование (для определения фенотипа злокачественных клеток);
- цитогенетический анализ;
- биопсия костного мозга и лимфатических узлов;
- пункции костного (стернальная) и спинного (люмбальная) мозга;
- визуализирующие исследования (рентген, КТ, МРТ) для выявления метастатических очагов в определенных внутренних органах.
Третий день
Специализированный междисциплинарный консилиум рассматривает результаты проведенных исследований. Врачи коллегиально определяются с конечным диагнозом и составляют план лечения.
Сколько стоит лечение
После завершения курса противоопухолевой терапии определяется итоговая цена, которая зависит от многих факторов. У консультанта клиники можно узнать ориентировочную стоимость предстоящего лечения.
Преимущества лечения в Израиле
- Высокая квалификация врачей.
- Применение инновационных методов терапии.
- Быстрая точная диагностика.
- Комфорт и четкая организация лечения.
- Доступные цены.
Зарубежные пациенты могут пройти онлайн-консультацию ведущего врача израильской клиники. Для этого необходимо подать заявку консультанту клиники и в условленное время связаться с врачом. Онколог даст оценку текущей ситуации, порекомендует варианты будущего лечения.







